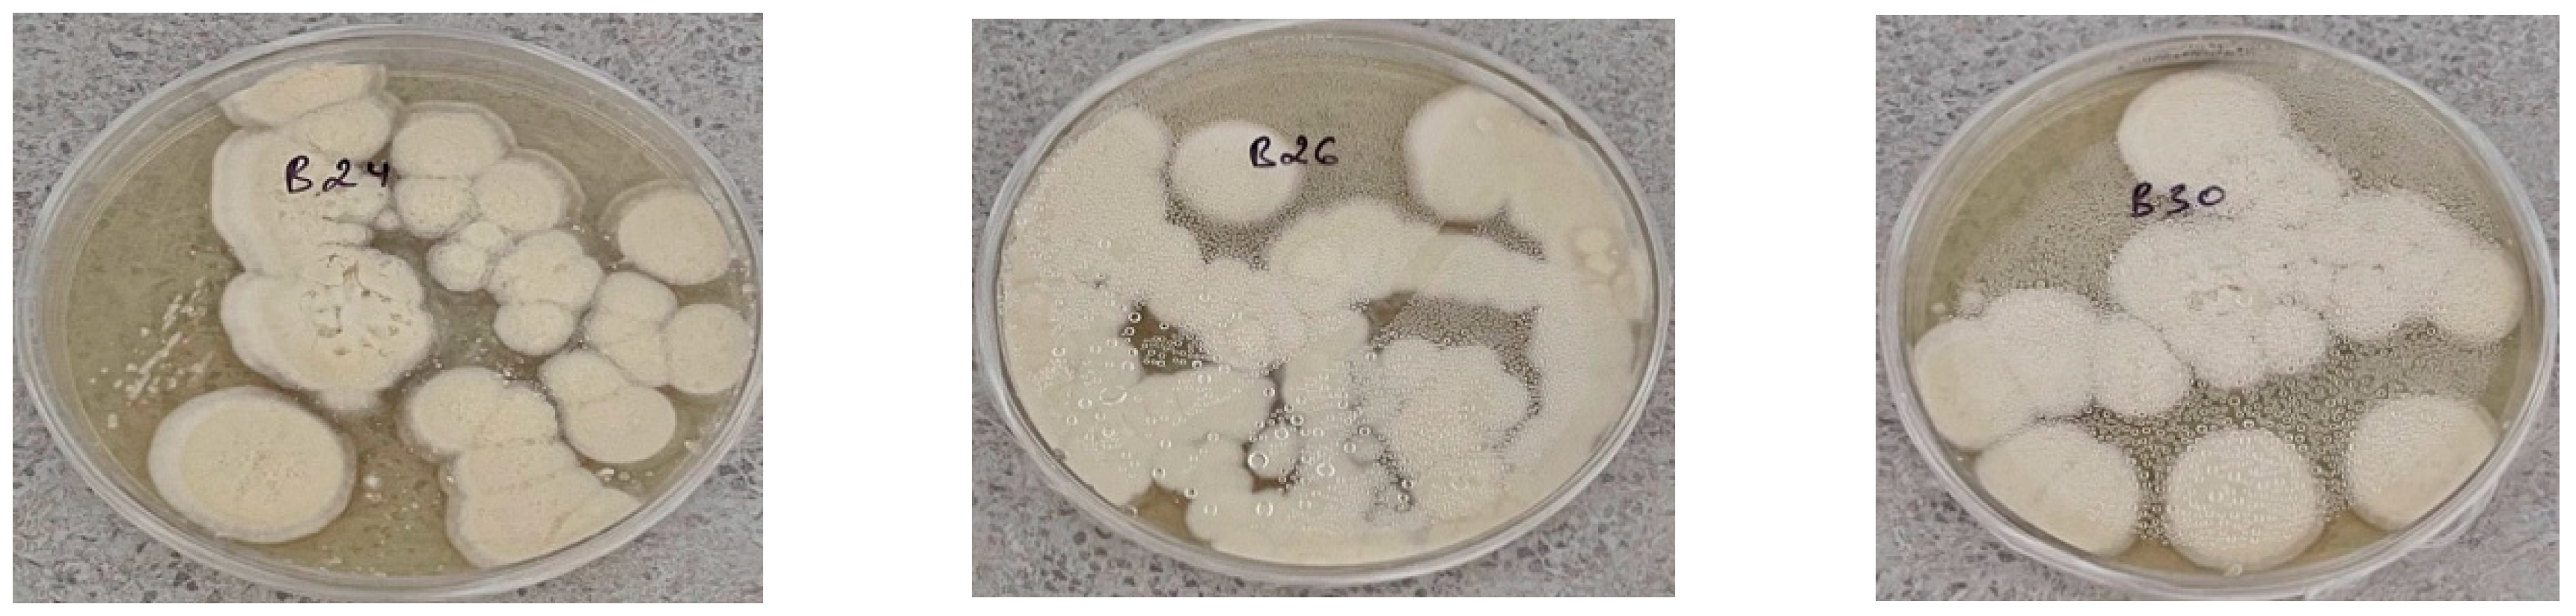
Preprints 118998 g002a

Submitted:
23 September 2024
Posted:
23 September 2024
You are already at the latest version
Abstract
Keywords:
1. Introduction
2. Materials and Methods
2.1. Sample Collection and Fungal Isolation
2.2. EPF Species Identification
2.3. Determining the Effect of Temperature on the Radial Growth of Anamorphic Ascomycetes
2.4. Determining the Viability of Conidia
2.5. Preparation of the Working Suspension and Determination of Titer Using the Goryaev Chamber
2.6. Laboratory Evaluation of Biological Activity
2.7. Statistical Analysis
3. Results
3.1. Species Composition of Entomopathogenic Fungi
3.2. Influence of Air Temperature on the Growth AND Viability of EPF
3.3. Viability of Fungal Conidia at Different Temperature Regimes
3.4. Assessment of the Virulence of Natural Entomopathogenic Fungal Isolates against Colorado Potato Beetle Larvae
4. Discussion
5. Conclusions
Author Contributions
Funding
Data Availability Statement
Acknowledgments
Conflicts of Interest
References
- Weber, D. Colorado beetle: Pest on the move. Pesticide Outlook 2003, 14, 256–269. [Google Scholar] [CrossRef]
- Weber, D. Biological Control of Potato Insect Pests. Insect Pests of Potato. Academic Press is an imprint of Elsevier, 2012, 399-437.
- Alyokhin, A.V.; Baker, M.; Mota-Sanchez, D.; Dively, G.; Grafius, E. Colorado Potato Beetle Resistance to Insecticides. American Journal of Potato Research 2008, 85, 395–413. [Google Scholar] [CrossRef]
- Li, C.; Liu, H.; Huang, F.; Cheng, D.; Wang, J.; Zhang, Y.; Sun, J.; Guo, W. Effect of Temperature on the Occurrence and Distribution of Colorado Potato Beetle (Coleoptera: Chrysomelidae) in China. Environmental Entomology 2014, 43, 511–519. [Google Scholar] [CrossRef]
- Khairushev, E.K. Potato Colorado potato beetle and ways to combat it. Almaty, 1992, 1-6.
- Alyokhin, A.; Rondon, S.I.; Gao, Y. Insect pests of potato: global perspectives on biology and management. Academic Press, 2022, 501.
- Guo, W.; Li, C.; Ahemati, T.; Jiang, W.; Li, G.; Wu, G.; Fu, K. Colorado Potato Beetle Leptinotarsa decemlineata (Say). Biological Invasions and Its Management in China. Invading Nature - Springer Series in Invasion Ecology, Springer, Dordrecht, 2017, 11, 195-217.
- Wang, C.; Xu, H.; Pan, X. Management of Colorado potato beetle in invasive frontier areas. Journal of Integrative Agriculture 2020, 19, 360–366. [Google Scholar] [CrossRef]
- Almarinez, B.J.M.; Amalin, D.M.; Aviso, K.B.; Cabezas, H.; Lao, A.R.; Tan, R.R. Network Modeling for Post-Entry Management of Invasive Pest Species in the Philippines: The Case of the Colorado Potato Beetle, Leptinotarsa decemlineata (Say, 1824) (Coleoptera: Chrysomelidae). Insects 2023, 14, 731. [Google Scholar] [CrossRef] [PubMed]
- Wang, C.; Hawthorne, D.; Qin, Y.; Pan, X.; Li, Z.; Zhu, S. Impact of climate and host availability on future distribution of Colorado potato beetle. Scientific Reports 2017, 7, 1–9. [Google Scholar] [CrossRef]
- Liao, J.; Liu, J.; Li, C. Effects of Repeated Short-Term Heat Exposure on Life History Traits of Colorado Potato Beetle. Insects 2022, 13, 455. [Google Scholar] [CrossRef]
- Pulatov, B.; Hall, K.; Linderson, M.L.; Jönsson, A.M. Effect of climate change on the potential spread of the Colorado potato beetle in Scandinavia: an ensemble approach. Clim Res 2014, 62, 15–24. [Google Scholar] [CrossRef]
- Pulatov, B.; Jönsson, A.M.; Wilcke, R.A.; Linderson, M.; Hall, K.; Bärring, L. Evaluation of the phenological synchrony between potato crop and Colorado potato beetle under future climate in Europe. Agriculture, Ecosystems & Environment 2016, 224, 39–49. [Google Scholar]
- Deutsch, C.A.; Tewksbury, J.J.; Tigchelaar, M.; Battisti, D.S.; Merrill, S.C.; Huey, R.B.; Naylor, R.L. Increase in crop losses to insect pests in a warming climate. Science 2018, 1–4. [Google Scholar] [CrossRef] [PubMed]
- Kroschel, J.; Mujica, N.; Okonya, J.; Alyokhin, A. Insect Pests Affecting Potatoes in Tropical, Subtropical, and Temperate Regions. The Potato Crop. Springer, Cham, 2020, 251-306.
- Skendžic ́,S. ; Zovko, M.; Živkovic ́, I.P.; Lešic ́, V.; Lemic ́, D. The Impact of Climate Change on Agricultural Insect Pests. Insects 2021, 12, 440. [Google Scholar] [CrossRef] [PubMed]
- Sablon, L.; Dickens, J.C.; Haubruge, É.; Verheggen, F.J. Chemical Ecology of the Colorado Potato Beetle, Leptinotarsa decemlineata (Say) (Coleoptera: Chrysomelidae), and Potential for Alternative Control Methods. Insects 2013, 4, 31–54. [Google Scholar] [CrossRef]
- Bastarache, P.; Timani, K.; Ben Youssef, M.; Omakele, E.; Vickruck, J.L.; Morin, P.J. Cyantraniliprole and Thiamethoxam Exposure Changes Expression of Transcripts Associated with Small Non-Coding RNA Processing in the Colorado Potato Beetle. Insects 2024, 15, 147. [Google Scholar] [CrossRef]
- Bouafoura, R.; Bastarache, P.; Ouédraogo, B.C.; Dumas, P.; Moffat, C.E.; Vickruck, J.L.; Morin, P.J. Characterization of Insecticide Response-Associated Transcripts in the Colorado Potato Beetle: Relevance of Selected Cytochrome P450s and Clothianidin. Insects 2022, 13, 505. [Google Scholar] [CrossRef] [PubMed]
- Kadoić Balaško, M.; Mikac, K.M.; Bažok, R.; Lemic, D. Modern Techniques in Colorado Potato Beetle (Leptinotarsa decemlineata Say) Control and Resistance Management: History Review and Future Perspectives. Insects 2020, 11, 581. [Google Scholar] [CrossRef]
- Kaleem Ullah, R.M.; Gökçe, A.; Bakhsh, A.; Salim, M.; Wu, H.Y.; Naqqash, M.N. Insights into the Use of Eco-Friendly Synergists in Resistance Management of Leptinotarsa decemlineata (Coleoptera: Chrysomelidae). Insects 2022, 13, 846. [Google Scholar] [CrossRef]
- Timani, K.; Bastarache, P.; Morin, P.J. Leveraging RNA Interference to Impact Insecticide Resistance in the Colorado Potato Beetle, Leptinotarsa decemlineata. Insects 2023, 14, 418. [Google Scholar] [CrossRef]
- Liu, D.; Smagghe, G.; Liu, T.-X. Interactions between Entomopathogenic Fungi and Insects and Prospects with Glycans. J. Fungi 2023, 9, 575. [Google Scholar] [CrossRef]
- Venkatesh, G.; Sakthi Priya, P.; Anithaa, V.; Dinesh, G.K.; Velmurugan, S.; Abinaya, S.; Karthika, P.; Sivasakthivelan, P.; Soni, R.; Thennarasi, A. Role of entomopathogenic fungi in biocontrol of insect pests. Plant Protection: From Chemicals to Biologicals 2022, 505-548.
- Sujeetha, J.A.R.P.; Sahayaraj, K. Role of Entomopathogenic Fungus in Pest Management. Basic and Applied Aspects of Biopesticides. Springer, New Delhi, 2014, 36-41.
- Charnley, A.K.; Collins, S.A. Entomopathogenic fungi and their role in pest control. The Mycota IV: Environmental and Microbial Relationships, 2nd edition, Springer, 2007, 159-187.
- Lacey, L.A.; Kaya, H.K. Field Manual of Techniques in Invertebrate Pathology. Application and Evaluation of Pathogens for Control of Insects and Other Invertebrate Pests, 2nd Edition, Springer, Dordrecht, 2007, 868.
- Mascarin, G.M.; Jaronski, S.T. The production and uses of Beauveria bassiana as a microbial insecticide. World J Microbiol Biotechnol 2016, 32, 177. [Google Scholar] [CrossRef]
- Liu, D.; Smagghe, G.; Liu, T.X. Interactions between Entomopathogenic Fungi and Insects and Prospects with Glycans. J. Fungi 2023, 9, 575. [Google Scholar] [CrossRef] [PubMed]
- Mannino, M.C.; Pedrini, N. Is the Insect Cuticle the only Entry Gate for Fungal Infection? Insights into Alternative Modes of Action of Entomopathogenic Fungi. Journal of Fungi 2019, 5, 33. [Google Scholar] [CrossRef] [PubMed]
- Lee, S.J.; Lee, M.R.; Kim, S.; Kim, J.C.; Park, S.E.; Li, D.; Shin, T.Y.; Nai, S.; Kim, J.S. Genomic Analysis of the Insect-Killing Fungus Beauveria bassiana JEF-007 as a Biopesticide. Scientific Reports 2018, 8, 1–12. [Google Scholar] [CrossRef] [PubMed]
- Zhang, Y.; Zhang, J.; Jiang, X.; Wang, G.; Luo, Z.; Fan, Y.; Wu, Z.; Pei, Y. Requirement of a Mitogen-Activated Protein Kinase for Appressorium Formation and Penetration of Insect Cuticle by the Entomopathogenic Fungus Beauveria bassiana. Applied and Environmental Microbiology 2010, 76, 2262–2270. [Google Scholar] [CrossRef] [PubMed]
- Ahirwar, N.K.; Singh, R. Assessing the Safety and E ciency of Entomopathogenic Fungi as Bioinsec cides: A Brief Review. Journal of Earth & Environmental Waste Management 2023, 1, 1–6. [Google Scholar]
- Fernandes, E.K.K.; Bittencourt, V.R.E.P.; Roberts, D.W. Perspectives on the potential of entomopathogenic fungi in biological control of ticks. Exp Parasitol 2012, 130, 300–305. [Google Scholar] [CrossRef]
- Khan, S.; Guo, L.; Maimaiti, Y.; Mijit, M.; Qiu, D. Entomopathogenic fungi as microbial biocontrol agent. Mol Plant Breed 2012, 3, 63–79. [Google Scholar] [CrossRef]
- Valero-Jiménez, C.A.; Wiegers, H.; Zwaan, B.J.; Koenraadt, C.J.M.; van Kan, J.A.L. Genes involved in virulence of the entomopathogenic fungus Beauveria bassiana. Journal of Invertebrate Pathology 2016, 133, 41–49. [Google Scholar] [CrossRef]
- Sui, L.; Lu, Y.; Zhou, L.; Li, N.; Li, Q.; Zhang, Z. Endophytic Beauveria bassiana promotes plant biomass growth and suppresses pathogen damage by directional recruitment. Frontiers in Microbiology 2023, 14, 1227269. [Google Scholar] [CrossRef]
- González-Mas, N.; Valverde-García, R.; Gutiérrez-Sánchez, F.; Quesada-Moraga, E. Effect of passage through the plant on virulence and endophytic behavioural adaptation in the entomopathogenic fungus Beauveria bassiana. Biological Control 2021, 160, 104687. [Google Scholar] [CrossRef]
- Abidin, A.F.; Ekowati, N.; Ratnaningtyas, N.I. Insecticide compatibility to the entomopathogenic fungi Beauveria bassiana and Metarhizium anisopliae. Scripta Biologica 2017, 4, 273–279. [Google Scholar] [CrossRef]
- Ondráčková, E.; Seidenglanz, M.; Šafář, J. Effect of seventeen pesticides on mycelial growth of Akanthomyces, Beauveria, Cordyceps and Purpureocillium strains. Czech Mycology 2019, 71, 123–135. [Google Scholar] [CrossRef]
- Mantzoukas, S.; Kitsiou, F.; Natsiopoulos, D.; Eliopoulos, P.A. Entomopathogenic Fungi: Interactions and Applications. Encyclopedia 2022, 2, 646–656. [Google Scholar] [CrossRef]
- Mascarin, G.M.; Marinho-Prado, J.S.; Assalin, M.R.; Martins, L.G.; Braga, E.S.; Tasic, L.; Dita, M.; Lopes, R.B. Natural occurrence of Beauveria caledonica, pathogenicity to Cosmopolites sordidus and antifungal activity against Fusarium oxysporum f. Sp. Cubense. Pest Management Science 2022, 78, 4458–4470. [Google Scholar] [CrossRef]
- St. Leger, R.J.; Wang, C. Genetic engineering of fungal biocontrol agents to achieve greater efficacy against insect pests. Appl.Microbiol.Biotechnol 2010, 85, 901–907. [Google Scholar] [CrossRef]
- Araújo, J.; Hughes, D. Diversity of Entomopathogenic Fungi: Which Groups Conquered the Insect Body? Advances in Genetics 2015, 94, 1–39. [Google Scholar]
- Mora, M.A.E.; Castilho, A.M.C.; Fraga, M.E. Classification and infection mechanism of entomopathogenic fungi. Arquivos Do Instituto Biológico 2017, 84, 1–10. [Google Scholar] [CrossRef]
- Bihal, R.; Al-Khayri, J.M.; Banu, A.N.; Kudesia, N.; Ahmed, F.K.; Sarkar, R.; Arora, A.; Abd-Elsalam, K.A. Entomopathogenic Fungi: An Eco-Friendly Synthesis of Sustainable Nanoparticles and Their Nanopesticide Properties. Microorganisms 2023, 11, 1617. [Google Scholar] [CrossRef]
- Humber, R. Seeking stability for research and applied uses of entomopathogenic fungi as biological control agents. J Asia Pac Entomol 2010, 19, 1019–1025. [Google Scholar] [CrossRef]
- Zimmermann, G. Review on safety of the entomopathogenic fungi Beauveria bassiana and Beauveria brongniartii. Biocontrol Science and Technology 2007, 17, 553–596. [Google Scholar] [CrossRef]
- Meyling, N.V.; Hajek, A.E. Principles from community and metapopulation ecology: application to fungal entomopathogens. The Ecology of Fungal Entomopathogens. Springer, Dordrecht, 2009, 39-54.
- Faria, M.R.D.; Wraight, S.P. Mycoinsecticides and Mycoacaricides: A comprehensive list with worldwide coverage and international classification of formulation types. Biological Control 2007, 43, 237–256. [Google Scholar] [CrossRef]
- Jaronski, S.; Mascarin, G. Mass Production of Fungal Entomopathogens. Microbial Control of Insect and Mite Pests 2016, 141–155. [Google Scholar]
- Smagghe, F.; Spooner-Hart, R.; Chen, Z.; Donovan-Mak, M. Biological control of arthropod pests in protected cropping by employing entomopathogens: Efficiency, production and safety. Biological Control 2023, 186, 105337. [Google Scholar] [CrossRef]
- Wang, C.; Fan, M.; Li, Z.; Butt, T.M. Molecular monitoring and evaluation of the application of the insect-pathogenic fungus Beauveria bassiana in southeast China. Journal of Applied Microbiology 2004, 96, 861–870. [Google Scholar] [CrossRef]
- Li, Z.; Alves, S.B.; Roberts, D.W.; Fan, M.; Delalibera, I.; Tang, J.; Rangel, D.E.N. Biological control of insects in Brazil and China: history, current programs and reasons for their successes using entomopathogenic fungi. Biocontrol Science and Technology 2009, 20, 117–136. [Google Scholar] [CrossRef]
- Kryukov, V.Y.; Yaroslavtseva, O.N.; Levchenko, M.V. Phenotypic variability of environmental isolates of the entomopathogenic fungus Beauveria bassiana. Microbiology 2010, 79, 265–269. [Google Scholar] [CrossRef]
- Valero-Jiménez, C.A.; Wiegers, H.; Zwaan, B.J.; Koenraadt, C.J.; Van Kan, J.A. Genes involved in virulence of the entomopathogenic fungus Beauveria bassiana. Journal of Invertebrate Pathology 2015, 133, 41–49. [Google Scholar] [CrossRef]
- Clifton, E.H.; Castrillo, L.A.; Jaronski, S.T.; Hajek, A.E. Cryptic diversity and virulence of Beauveria bassiana recovered from Lycorma delicatula (spotted lanternfly) in eastern Pennsylvania. Front. Insect Sci 2023, 3, 1127682. [Google Scholar] [CrossRef]
- Liu, J.; Ling, Z.; Wang, J.; Xiang, T.; Xu, L.; Gu, C.; Liu, R.; Xu, J.; Xu, C.; Zhou, W.; Liu, Y.; Jin, Z.; Wan, Y. In vitro transcriptomes analysis identifies some special genes involved in pathogenicity difference of the Beauveria bassiana against different insect hosts. Microbial Pathogenesis 2021, 154, 104824. [Google Scholar] [CrossRef]
- St Leger, R.J. Integument as a Barrier to Microbial Infections. Physiology of the Insect Epidermis. Commonwealth Scientific and Industrial Research Organization, Melbourne, 1991, 286-308.
- Fargues, J.; Goettel, M.S.; Smits, N.; Ouedraogo, A.; Rougier, M. Effect of Temperature on Vegetative Growth of Beauveria bassiana Isolates from Different Origins. Mycologia 1997, 89, pp. 383–392.
- Fernandes, É.K.; Rangel, D.E.; Moraes, Á.M.; Bittencourt, V.R.; Roberts, D.W. Cold activity of Beauveria and Metarhizium, and thermotolerance of Beauveria. Journal of Invertebrate Pathology 2008, 98, 69–78. [Google Scholar] [CrossRef]
- de la Cruz Quiroz, R.; Cruz Maldonado, J.; Rostro Alanis, M. Fungi-based biopesticides: shelf-life preservation technologies used in commercial products. J Pest Sci 2019, 92, 1003–1015. [Google Scholar] [CrossRef]
- Tong, M.; Feng, G. Molecular basis and regulatory mechanisms underlying fungal insecticides’ resistance to solar ultraviolet irradiation. Pest Management Science 2021, 78, 30–42. [Google Scholar] [CrossRef] [PubMed]
- Bayramoğlu, Z. The UV protectant properties of tea extracts on entomopathogenic fungus spores and their lethal effect on Galleria mellonella (L., 1758) (Lepidoptera: Pyralidae). Turkish Journal of Entomology 2023, 47, 363–372. [Google Scholar] [CrossRef]
- Friuli, M.; Pellegrino, R.; Lamanna, L.; Nitti, P.; Madaghiele, M.; Demitri, C. Materials Engineering to Help Pest Control: A Narrative Overview of Biopolymer-Based Entomopathogenic Fungi Formulations. J. Fungi 2023, 9, 918. [Google Scholar] [CrossRef] [PubMed]
- Holka, M.; Kowalska, J. The Potential of Adjuvants Used with Microbiological Control of Insect Pests with Emphasis on Organic Farming. Agriculture 2023, 13, 1659. [Google Scholar] [CrossRef]
- Gerding-González, M.; France, A.; Sepulveda, M.E.; Campos, J. Use of chitin to improve a Beauveria bassiana alginate-pellet formulation. Biocontrol Science and Technology 2007, 17, 105–110. [Google Scholar] [CrossRef]
- Nong, X.; Wang, G.; Zhang, X.; Liu, X.; Zhang, Z. Alginate Granule formulation promotes recovery of metarhizium anisopliae population. Chinese Journal of Biological Control 2016, 32, 762. [Google Scholar]
- Batista, D.P.C.; De Oliveira, I.N.; Ribeiro, A.R.B.; Fonseca, E.J.S.; Santos-Magalhães, N.S.; de Sena-Filho, J.G.; Dornelas, C.B. Encapsulation and release of Beauveria bassiana from alginate–bentonite nanocomposite. RSC advances 2017, 7, 26468–26477. [Google Scholar] [CrossRef]
- Shah, S.; Ash, G.J.; L. Wilson, B.A. Resporulation of Metarhizium anisopliae granules on soil and mortality of Tenebrio molitor: Implications for wireworm management in sweetpotato. Annals of Applied Biology 2022, 182, 65–76. [Google Scholar] [CrossRef]
- Keyser, C.A.; De Fine Licht, H.H.; Steinwender, B.M.; Meyling, N.V. Diversity within the entomopathogenic fungal species Metarhizium flavoviride associated with agricultural crops in Denmark. BMC Microbiology 2015, 15, 1–11. [Google Scholar] [CrossRef]
- Imoulan, A.; Hussain, M.; Kirk, P.M.; El Meziane, A.; Yao, Y. Entomopathogenic fungus Beauveria: Host specificity, ecology and significance of morpho-molecular characterization in accurate taxonomic classification. Journal of Asia-Pacific Entomology 2017, 20, 1204–1212. [Google Scholar] [CrossRef]
- Lovett, B.; St. Leger, R.J. The insect pathogens. Microbiol. Spectr 2017, 5, 923–943. [Google Scholar] [CrossRef] [PubMed]
- Imoulan, A.; Wei, X.D.; Wang, W.J. Distribution and genetic diversity of Beauveria species at different soil depths in natural and agricultural ecosystems. Mycol Progress 2019, 18, 1241–1252. [Google Scholar] [CrossRef]
- Meyling, N.V.; Eilenberg, J. Occurrence and distribution of soil borne entomopathogenic fungi within a single organic agroecosystem. Agriculture, Ecosystems & Environment 2006, 113, 336–341. [Google Scholar]
- Meyling, N.V. Methods for isolation of entomopathogenic fungi from the soil environment. Laboratory manual, Denmark, 2007, 1-18.
- Zimmermann, G. The ‘Galleria bait method’ for detection of entomopathogenic fungi in soil. Journal of Applied Entomology 1986, 102, 213–215. [Google Scholar] [CrossRef]
- Keller, S.; Kessler, P.; Schweizer, C. Distribution of insect pathogenic soil fungi in Switzerland with special reference to Beauveria brongniartii and Metharhizium anisopliae. BioControl 2003, 48, 307–319. [Google Scholar] [CrossRef]
- Montesinos, M.R.; Viniegra Gonzalez, G.; Alatorre Rosas, R.; Loera, O. Relationship between virulence and enzymatic profiles in the cuticle of Tenebrio molitor by 2-deoxy-D-glucose-resistant mutants of Beauveria bassiana (Bals.) Vuill. World J. Microbiol Biotechnol 2011, 27, 2095–2102. [Google Scholar] [CrossRef]
- Juliya, R.F. Genetic diversity of Beauveria bassiana in semi natural and agricultural habitats and its biocontrol potential against cowpea aphid, Aphis craccivora Koch. Braz J Microbiol 2019, 50, 697–704. [Google Scholar] [CrossRef]
- Karaborklu, S.; Altin, N.; Keskin, Y. Native entomopathogenic fungi isolated from Duzce, Turkey and their virulence on the mealworm beetle [Tenebrio molitor L. (Coleoptera: Tenebrionidae)]. Journal Article 2019, 4395.
- Gebremariam, A.; Chekol, Y.; Assefa, F. Phenotypic, molecular, and virulence characterization of entomopathogenic fungi, Beauveria bassiana (Balsam) Vuillemin, and Metarhizium anisopliae (Metschn.) Sorokin from soil samples of Ethiopia for the development of mycoinsecticide. Heliyon 2021, 7, e07091. [Google Scholar] [CrossRef]
- Enkerli, J.; Widmer, F. Molecular ecology of fungal entomopathogens: molecular genetic tools and their applications in population and fate studies. BioControl 2010, 55, 17–37. [Google Scholar] [CrossRef]
- Rehner, S.A. Phylogenetics of the insect pathogenic genus Beauveria. Insect-fungal associations: Ecology and evolution. Oxford University Press, Oxford, 2005, 3-27.
- Rehner, S.A.; Buckley, E. A Beauveria phylogeny inferred from nuclear ITS and EF1-α sequences: evidence for cryptic diversification and links to Cordyceps teleomorphs. Mycologia 2005, 97, 84–98. [Google Scholar] [CrossRef] [PubMed]
- Rehner, S.A.; Minnis, A.M.; Sung, G.H.; Luangsa-ard, J.J.; Devotto, L.; Humber, R.A. Phylogeny and systematics of the anamorphic, entomopathogenic genus Beauveria. Mycologia 2011, 103, 1055–1073. [Google Scholar] [CrossRef] [PubMed]
- Humber, R.A. Identification of entomopathogenic fungi. Manual of Techniques in Invertebrate Pathology. Cornell University, 2nd Edition, 2011, 151-187.
- Kryukov, V.Y.; Yaroslavtseva, O.N.; Elisaphenko, E.A. Change in the temperature preferences of Beauveria bassiana sensu lato isolates in the latitude gradient of Siberia and Kazakhstan. Microbiology 2012, 81, 453–459. [Google Scholar] [CrossRef]
- Makarov, E.M.; Baimagambetov, E.J.; Lednev, G.R. Methodological guidelines for assessing the biological effectiveness of strains of the entomopathogenic fungus Beauveria bassiana S.L. (Bals.) Vuill in relation to locusts. Astana, 2015, 17.
- Abbott, W.S. A method of computing the effectiveness of an insecticide. J. econ. Entomol 1925, 18, 265–267. [Google Scholar] [CrossRef]
- Tuininga, A.R.; Miller, J.L.; Morath, S.U.; Daniels, T.J.; Falco, R.C.; Marchese, M.; Sahabi, S.; Rosa, D.; Stafford, K.C. Isolation of Entomopathogenic Fungi From Soils and Ixodes scapularis (Acari: Ixodidae) Ticks: Prevalence and Methods. Journal of Medical Entomology 2009, 46, 557–565. [Google Scholar] [CrossRef]
- Korosi, G.A.; Wilson, B.A.; Powell, K.S.; Ash, G.J.; Reineke, A.; Savocchia, S. Occurrence and diversity of entomopathogenic fungi (Beauveria spp. And Metarhizium spp.) in Australian vineyard soils. Journal of Invertebrate Pathology 2019, 164, 69–77. [Google Scholar] [CrossRef]
- Berestetskiy, A.O.; Ivanova, A.N.; Petrova, M.O. Comparative Analysis of the Biological Activity and Chromatographic Profiles of the Extracts of Beauveria bassiana and B. pseudobassiana Cultures Grown on Different Nutrient Substrates. Microbiology 2018, 87, 200–214. [Google Scholar] [CrossRef]
- Imoulan, A.; Hussain, M.; Kirk, P.M.; El Meziane, A.; Yao, Y. Entomopathogenic fungus Beauveria: Host specificity, ecology and significance of morpho-molecular characterization in accurate taxonomic classification. Journal of Asia-Pacific Entomology 2017, 20, 1204–1212. [Google Scholar] [CrossRef]
- Imoulan, A.; Wu, H.; Lu, W.; Li, Y.; Li, B.; Yang, R.; Wang, W.; Wang, X.; Kirk, P.M.; Yao, Y. Beauveria medogensis sp. Nov., a new fungus of the entomopathogenic genus from China. Journal of Invertebrate Pathology 2016, 139, 74–81. [Google Scholar] [CrossRef]
- Meyling, N.V.; Pilz, C.; Keller, S.; Widmer, F.; Enkerli, J. Diversity of Beauveria spp. isolates from pollen beetles Meligethes aeneus in Switzerland. J Invertebr Pathol 2012, 109, 76–82. [Google Scholar] [CrossRef]
- Kazartsev, I.A.; Lednev, G.R. Distribution and Diversity of Beauveria in Boreal Forests of Northern European Russia. Microorganisms 2021, 9, 1409. [Google Scholar] [CrossRef] [PubMed]
- Abdukerim, R.; Lednev, G.; Trýzna, M.; Ryšánek, P.; Zouhar, M. Comparison Analysis of Species Composition of Entomopathogenic Fungi Isolated from Bark Beetles (Coleoptera: Scolytidae). OnLine Journal of Biological Sciences 2018, 18, 62–68. [Google Scholar] [CrossRef]
- Vidal, C.; Fargues, J. Climatic constraints for fungal bioinsecticides. Use of Entomopathogenic Fungi in Biological Pest Management, 2007, 39–55.
- Lednev, G.R.; Uspanov, A.M.; Tokarev, Y.S.; Kazartsev, I.A.; Levchenko, M.V.; Sabitova, M.N.; Smagulova, S.B.; Duisembekov, B.A. Biological features of strains of two species of fungi of the genus Beauveria of northern Eurasia. Proceedings of the All-Russian conference with international participation “Biodiversity and ecology of fungi and mushroom-like organisms of Northern Eurasia”. Yekaterinburg, 2015, 139-141.
- Kryukov, V.Y.; Yaroslavtseva, O.N.; Elisaphenko, E.A. Change in the temperature preferences of Beauveria bassiana sensu lato isolates in the latitude gradient of Siberia and Kazakhstan. Microbiology 2012, 81, 453–459. [Google Scholar] [CrossRef]
- Zemek,R. ; Konopická,J.; Jozová, E.; Skoková Habuštová, O. Virulence of Beauveria bassiana Strains Isolated from Cadavers of Colorado Potato Beetle, Leptinotarsa decemlineata. Insects 2021, 12, 1077. [Google Scholar] [CrossRef] [PubMed]
- Yıldırım, K.; Eski, A.; Biryol, S. Isolation, Characterization, and Formulation of Indigenous Beauveria bassiana Fungus Against Colorado Potato Beetle, Leptinotarsa decemlineata (Coleoptera: Chrysomelidae). Potato Res 2024, 67, 583–601. [Google Scholar] [CrossRef]
- Polat, İ.; Yanar, Y.; Yanar, D. Efficacy of local entomopathogenic fungi isolated from forestlands in Tokat Province (Türkiye) against the Colorado potato beetle, Leptinotarsa decemlineata (Say, 1824) (Coleoptera: Chrysomelidae). Turkish Journal of Entomology 2022, 46, 159–173. [Google Scholar] [CrossRef]
- Kryukov, V.Y. Adaptations of entomopathogenic ascomycetes (Ascomycota, Hypocreales) host insects and environmental factors in the continental climate of western Siberia and Kazakhstan. Dissertation for the degree of Doctor of Biological Sciences. Novosibirsk, 2014, P. 249. https://www.dissercat.com/content/adaptatsii-entomopatogennykh-askomitsetov-ascomycota-hypocreales-k-nasekomym-khozyaevam-i.
- Uzun, Y.A.; Göze Özdemir, F.G.; Demirözer, O.; Nayır, T. Efficacy of single and combined applications of entomopathogenic fungi and nematodes against the pupae of colorado potato beetle (Leptinotarsa decemlineata [Say]), (Coleoptera: Chrysomelidae). Egyptian Journal of Biological Pest Control 2022, 32, 1–6. [Google Scholar] [CrossRef]
- Pu ̊ža,V. ; Nermut’,J.; Konopická, J.; Skoková Habuštová, O. Efficacy of the Applied Natural Enemies on the Survival of Colorado Potato Beetle Adults. Insects 2021, 12, 1030. [Google Scholar] [CrossRef]

| № | Isolates | Type species in Genbank by ITS locus |
Number of genes read | Other similar species | Type species in Genbank for TEF locus | Number of genes read | Other similar species |
| 1 | B9 |
B. pseudobassiana ARSEF 3405 |
614 |
B. majiangensis GZAC GZU1214 |
B. bassiana ARSEF 2860 | 1251 |
B. bassiana isolate ARSEF 815 Beauveria sp. KVL_03_136 |
| 2 | B10 |
B. pseudobassiana ARSEF 3405 |
940 |
B. majiangensis GZAC GZU1214 B. kipukae ARSEF 7032 |
B. bassiana ARSEF 2860 | 1250 |
B. bassiana isolate ARSEF 815 Beauveria sp. KVL_03_136 |
| 3 | B11 |
B. pseudobassiana ARSEF 3405 |
657 |
B.majiangensis GZAC GZU1214 B. bassiana ARSEF 1564 B.australis ARSEF 4598 |
B. bassiana ARSEF 2860 |
1244 |
B. bassiana isolate ARSEF 815 Beauveria sp. KVL_03_136 |
| 4 | B12 | B. bassiana ARSEF 1564 | 352 |
B. australis ARSEF 4598 B. varroae ARSEF 8257 B.majiangensis GZAC GZU1214 |
B. bassiana ARSEF 2860 | 1016 |
B. bassiana isolate ARSEF 815 B. bassiana isolate Bb5 B. bassiana isolate BbDm-1 |
| 5 | B13 | B. bassiana ARSEF 1564 | 588 |
B. australis ARSEF 4598 B. varroae ARSEF 8257 B.majiangensis GZAC GZU1214 B. lii ARSEF 11741 |
B. bassiana ARSEF 2860 | 1018 |
B. bassiana isolate ARSEF 815 B. bassiana isolate Bb5 B. bassiana isolate BbDm-1 |
| 6 | B14 | B. bassiana ARSEF 1564 | 701 |
B. australis ARSEF 4598 B. varroae ARSEF 8257 B. majiangensis GZAC GZU1214 B. pseudobassiana ARSEF 3405 B. lii ARSEF 11741 |
B. bassiana ARSEF 2860 |
1314 |
B. bassiana isolate ARSEF 815 B. bassiana isolate Bb5 B. bassiana isolate BbDm-1 |
| 7 | B15 | B. bassiana ARSEF 1564 | 465 |
B.australis ARSEF 4598 B.varroae ARSEF 8257 B.majiangensis GZAC GZU1214 B.amorpha ARSEF 2641 B. lii ARSEF 11741 |
B. bassiana ARSEF 2860 |
1029 |
B. bassiana isolate ARSEF 815 B. bassiana isolate Bb5 B. bassiana isolate BbDm-1 |
| 8 | B16 | B. bassiana ARSEF 1564 | 491 |
B. australis ARSEF 4598 B. varroae ARSEF 8257 B. majiangensis GZAC GZU1214 B. lii ARSEF 11741 |
B. bassiana ARSEF 2860 |
1028 |
B. bassiana isolate ARSEF 815 B. bassiana isolate Bb5 B. bassiana isolate BbDm-1 |
| 9 | B17 | B. bassiana ARSEF 1564 | 636 |
B. australis ARSEF 4598 B. varroae ARSEF 8257 B. majiangensis GZAC GZU1214 B. lii ARSEF 11741 B.amorpha ARSEF 2641 B. malawiensis IMI 228343 |
B. bassiana ARSEF 2860 |
1020 |
B. bassiana isolate ARSEF 815 B. bassiana isolate Bb5 B. bassiana isolate BbDm-1 |
| 10 | B18 | B. bassiana ARSEF 1564 | 690 |
B. australis ARSEF 4598 B. varroae ARSEF 8257 B. majiangensis GZAC GZU1214 B. lii ARSEF 11741 |
B. bassiana ARSEF 2860 |
1014 |
B. bassiana isolate ARSEF 815 B. bassiana isolate Bb5 B. bassiana isolate BbDm-1 |
| 11 | B19 | B. bassiana ARSEF 1564 | 343 |
B. australis ARSEF 4598 B. varroae ARSEF 8257 B. majiangensis GZAC GZU1214 |
B. bassiana ARSEF 2860 |
1017 |
B. bassiana isolate ARSEF 815 B. bassiana isolate Bb5 B. bassiana isolate BbDm-1 |
| 12 | B20 | B. bassiana ARSEF 1564 | 314 |
B. australis ARSEF 4598 B. varroae ARSEF 8257 B. majiangensis GZAC GZU1214 |
B. bassiana ARSEF 2860 |
1025 |
B. bassiana isolate ARSEF 815 B. bassiana isolate Bb5 B. bassiana isolate BbDm-1 |
| 13 | B21 | B. bassiana ARSEF 1564 | 646 |
B. australis ARSEF 4598 B. varroae ARSEF 8257 B. majiangensis GZAC GZU1214 B. lii ARSEF 11741 B. malawiensis IMI 228343 B.amorpha ARSEF 2641 |
B. bassiana ARSEF 2860 |
1015 |
B. bassiana isolate ARSEF 815 B. bassiana isolate Bb5 B. bassiana isolate BbDm-1 |
| 14 | B22 | B. bassiana ARSEF 1564 | 319 |
B. australis ARSEF 4598 B. varroae ARSEF 8257 B. majiangensis GZAC GZU1214 |
B. bassiana ARSEF 2860 |
1020 |
B. bassiana isolate ARSEF 815 B. bassiana isolate Bb5 B. bassiana isolate BbDm-1 |
| 15 | B23 | B. bassiana ARSEF 1564 | 462 |
B. australis ARSEF 4598 B. varroae ARSEF 8257 B. majiangensis GZAC GZU1214 |
B. bassiana ARSEF 2860 | 1016 |
B. bassiana isolate ARSEF 815 B. bassiana isolate Bb5 B. bassiana isolate BbDm-1 |
| 16 | B24 | B. bassiana ARSEF 1564 | 646 |
B. australis ARSEF 4598 B. varroae ARSEF 8257 Beauveria majiangensis GZAC GZU1214 B. lii ARSEF 11741 B. malawiensis IMI 228343 B.amorpha ARSEF 2641 |
B. bassiana ARSEF 2860 | 1028 |
B. bassiana isolate ARSEF 815 B. bassiana isolate Bb5 B. bassiana isolate BbDm-1 |
| 17 | B25 | B. bassiana ARSEF 1564 | 437 |
B. australis ARSEF 4598 B. varroae ARSEF 8257 B. majiangensis GZAC GZU1214 |
B. bassiana ARSEF 2860 |
1019 |
B. bassiana isolate ARSEF 815 B. bassiana isolate Bb5 B. bassiana isolate BbDm-1 |
| 18 | B26 | B. bassiana ARSEF 1564 | 524 |
B. australis ARSEF 4598 B. varroae ARSEF 8257 B. majiangensis GZAC GZU1214 |
B. bassiana ARSEF 2860 | 1023 |
B. bassiana isolate ARSEF 815 B. bassiana isolate Bb5 B. bassiana isolate BbDm-1 |
| 19 | B28 | B. bassiana ARSEF 1564 | 384 |
B. australis ARSEF 4598 B. majiangensis GZAC GZU1214 B. varroae ARSEF 8257 |
B. bassiana ARSEF 2860 | 1017 |
B. bassiana isolate ARSEF 815 B. bassiana isolate Bb5 B. bassiana isolate BbDm-1 |
| 20 | B29 | B. bassiana ARSEF 1564 | 575 |
B. australis ARSEF 4598 B. varroae ARSEF 8257 B. majiangensis GZAC GZU1214 B.amorpha ARSEF 2641 B. lii ARSEF 11741 |
B. bassiana ARSEF 2860 | 1016 |
B. bassiana isolate ARSEF 815 B. bassiana isolate Bb5 B. bassiana isolate BbDm-1 |
| 21 | B30 | B. bassiana ARSEF 1564 | 425 |
B. australis ARSEF 4598 B. varroae ARSEF 8257 B. majiangensis GZAC GZU1214 |
B. bassiana ARSEF 2860 | 1028 |
B. bassiana isolate ARSEF 815 B. bassiana isolate Bb5 B. bassiana isolate BbDm-1 |
| 22 | B53 | B. bassiana ARSEF 1564 | 352 |
B. australis ARSEF 4598 B. varroae ARSEF 8257 B. majiangensis GZAC GZU1214 |
B. bassiana ARSEF 2860 |
1011 |
B. bassiana isolate ARSEF 815 B. bassiana isolate Bb5 B. bassiana isolate BbDm-1 |
| 23 | B23-1 | B. bassiana ARSEF 1564 | 472 |
B. australis ARSEF 4598 B. varroae ARSEF 8257 B. majiangensis GZAC GZU1214 B. lii ARSEF 11741 |
B. bassiana ARSEF 2860 | 1019 |
B. bassiana isolate ARSEF 815 B. bassiana isolate Bb5 B. bassiana isolate BbDm-1 |
| 24 | B23-2 | B. bassiana ARSEF 1564 | 296 |
B. australis ARSEF 4598 B. varroae ARSEF 8257 B. majiangensis GZAC GZU1214 B. pseudobassiana ARSEF 3405 |
B. bassiana ARSEF 2860 | 1020 |
B. bassiana isolate ARSEF 815 Beauveria sp. KVL_03_136 |
| 25 | B23-3 |
B. pseudobassiana ARSEF 3405 |
724 |
B. majiangensis GZAC GZU1214 |
B. bassiana ARSEF 2860 | 1012 |
B. bassiana isolate ARSEF 815 Beauveria sp. KVL_03_136 |
| 26 | B23-9 |
B. pseudobassiana ARSEF 3405 |
574 |
B. bassiana ARSEF 1564 B. majiangensis GZAC GZU1214 B. australis ARSEF 4598 B. varroae ARSEF 8257 B.a malawiensis IMI 228343 B. kipukae ARSEF 7032 B. brongniartii ARSEF 617 |
B. bassiana ARSEF 2860 | 1021 |
B. bassiana isolate ARSEF 815 Beauveria sp. KVL_03_136 |
| 27 | B23-11 | B. bassiana ARSEF 1564 | 266 |
B. pseudobassiana ARSEF 3405 B. australis ARSEF 4598 B. majiangensis GZAC GZU1214 B. varroae ARSEF 8257 |
B. bassiana ARSEF 2860 | 1015 |
B. bassiana isolate ARSEF 815 B. bassiana isolate Bb5 B. bassiana isolate BbDm-1 |
| 28 | B23-13 | B. bassiana ARSEF 1564 | 394 |
B. australis ARSEF 4598 B. varroae ARSEF 8257 B. majiangensis GZAC GZU1214 B. lii ARSEF 11741 |
B. bassiana ARSEF 2860 | 1013 |
B. bassiana isolate ARSEF 815 Beauveria sp. KVL_03_136 |
| 29 | B23-14 | B. bassiana ARSEF 1564 | 640 |
B. australis ARSEF 4598 B. varroae ARSEF 8257 B. majiangensis GZAC GZU1214 B. lii ARSEF 11741 |
B. bassiana ARSEF 2860 |
1022 |
B. bassiana isolate ARSEF 815 B. bassiana isolate Bb5 B. bassiana isolate BbDm-1 |
| 30 | B23-17 | B. bassiana ARSEF 1564 | 755 |
B. australis ARSEF 4598 B. varroae ARSEF 8257 B. majiangensis GZAC GZU1214 B. malawiensis IMI 228343 B. lii ARSEF 11741 |
B. bassiana ARSEF 2860 |
1029 |
B. bassiana isolate ARSEF 815 B. bassiana isolate Bb5 B. bassiana isolate BbDm-1 |
| 31 | B23-18 | B. bassiana ARSEF 1564 | 846 |
B. australis ARSEF 4598 B. varroae ARSEF 8257 B. majiangensis GZAC GZU1214 B.amorpha ARSEF 2641 B. lii ARSEF 11741 |
B. bassiana ARSEF 2860 |
1022 |
B. bassiana isolate ARSEF 815 B. bassiana isolate Bb5 B. bassiana isolate BbDm-1 |
| 32 | B23-23 | B. bassiana ARSEF 1564 | 846 |
B. australis ARSEF 4598 B. varroae ARSEF 8257 B. majiangensis GZAC GZU1214 B.amorpha ARSEF 2641 B. lii ARSEF 11741 |
B. bassiana ARSEF 2860 |
1016 |
B. bassiana isolate ARSEF 815 B. bassiana isolate Bb5 B. bassiana isolate BbDm-1 |
| 33 | B23-25 |
B. pseudobassiana ARSEF 3405 |
882 |
B. majiangensis GZAC GZU1214 B. kipukae ARSEF 7032 |
B. bassiana ARSEF 2860 | 1013 |
B. bassiana isolate ARSEF 815 Beauveria sp. KVL_03_136 |
| 34 | B23-11 | B. bassiana ARSEF 1564 | 825 |
B. australis ARSEF 4598 B. varroae ARSEF 8257 B. majiangensis GZAC GZU1214 B.amorpha ARSEF 2641 B. malawiensis IMI 228343 B. lii ARSEF 11741 B. caledonica BCRC 32867 |
B. bassiana ARSEF 2860 | 1017 |
B. bassiana isolate ARSEF 815 B. bassiana isolate Bb5 B. bassiana isolate BbDm-1 |
| 35 | Bc2 | B. bassiana ARSEF 1564 | 432 |
B. australis ARSEF 4598 B. varroae ARSEF 8257 B. majiangensis GZAC GZU1214 B.amorpha ARSEF 2641 |
B. bassiana ARSEF 2860 | 1018 |
B. bassiana isolate ARSEF 815 B. bassiana isolate Bb5 B. bassiana isolate BbDm-1 |
| 36 | Bc3 | B. bassiana ARSEF 1564 | 394 |
B. australis ARSEF 4598 B. varroae ARSEF 8257 B. majiangensis GZAC GZU1214 B. lii ARSEF 11741 |
B. bassiana ARSEF 2860 | 1019 |
B. bassiana isolate ARSEF 815 B. bassiana isolate Bb5 B. bassiana isolate BbDm-1 |
| 37 | Bc4 | B. bassiana ARSEF 1564 | 652 |
B. australis ARSEF 4598 B. varroae ARSEF 8257 B. majiangensis GZAC GZU1214 B. lii ARSEF 11741 B.amorpha ARSEF 2641 |
B. bassiana ARSEF 2860 |
1024 |
B. bassiana isolate ARSEF 815 B. bassiana isolate Bb5 B. bassiana isolate BbDm-1 |
| 38 | Bc5 | B. bassiana ARSEF 1564 | 343 |
B. australis ARSEF 4598 B. varroae ARSEF 8257 B. majiangensis GZAC GZU1214 |
B. bassiana ARSEF 2860 | 1014 |
B. bassiana isolate ARSEF 815 B. bassiana isolate Bb5 B. bassiana isolate BbDm-1 |
| 39 | Bc6 | B. bassiana ARSEF 1564 | 329 |
B. australis ARSEF 4598 B. varroae ARSEF 8257 B. majiangensis GZAC GZU1214 |
B. bassiana ARSEF 2860 | 1020 |
B. bassiana isolate ARSEF 815 B. bassiana isolate Bb5 B. bassiana isolate BbDm-1 |
| 40 | Bc7 | B. bassiana ARSEF 1564 | 626 |
B. australis ARSEF 4598 B. varroae ARSEF 8257 B. majiangensis GZAC GZU1214 B.amorpha ARSEF 2641 B. malawiensis IMI 228343 |
B. bassiana ARSEF 2860 | 1022 |
B. bassiana isolate ARSEF 815 B. bassiana isolate Bb5 B. bassiana isolate BbDm-1 |
| 41 | Bc8 | B. bassiana ARSEF 1564 | 386 |
B. australis ARSEF 4598 B. varroae ARSEF 8257 B. majiangensis GZAC GZU1214 |
B. bassiana ARSEF 2860 | 1026 |
B. bassiana isolate ARSEF 815 B. bassiana isolate Bb5 B. bassiana isolate BbDm-1 |
Disclaimer/Publisher’s Note: The statements, opinions and data contained in all publications are solely those of the individual author(s) and contributor(s) and not of MDPI and/or the editor(s). MDPI and/or the editor(s) disclaim responsibility for any injury to people or property resulting from any ideas, methods, instructions or products referred to in the content. |
© 2024 by the authors. Licensee MDPI, Basel, Switzerland. This article is an open access article distributed under the terms and conditions of the Creative Commons Attribution (CC BY) license (http://creativecommons.org/licenses/by/4.0/).
